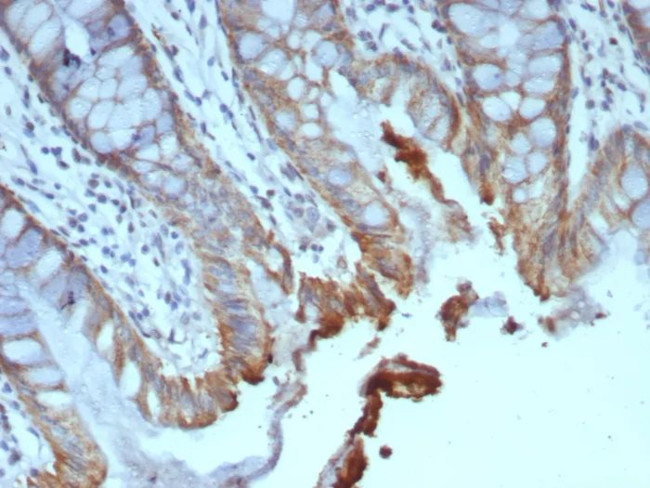
ICOS-L/ICOS Ligand/B7RP-1 (Immuno-Oncology Target) Antibody in Immunohistochemistry (Paraffin) (IHC (P))
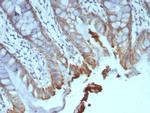
ICOS-L/ICOS Ligand/B7RP-1 (Immuno-Oncology Target) Antibody in Immunohistochemistry (Paraffin) (IHC (P))

Search
NeoBiotechnologies
ICOS-L/ICOS Ligand/B7RP-1 (Immuno-Oncology Target) Monoclonal Antibody (ICOSL/7700)
{{$productOrderCtrl.translations['antibody.pdp.commerceCard.promotion.promotions']}}
{{$productOrderCtrl.translations['antibody.pdp.commerceCard.promotion.viewpromo']}}
{{$productOrderCtrl.translations['antibody.pdp.commerceCard.promotion.promocode']}}: {{promo.promoCode}} {{promo.promoTitle}} {{promo.promoDescription}}. {{$productOrderCtrl.translations['antibody.pdp.commerceCard.promotion.learnmore']}}
产品信息
23308-MSM9-P1
种属反应
宿主/亚型
分类
类型
克隆号
抗原
偶联物
形式
浓度
规格
纯化类型
保存液
内含物
保存条件
运输条件
产品详细信息
Positive Control: HL60 HuT78 or HUVEC lysates (WB). Human tonsil tissue (IHC). U937
Cellular Location: Cell Surface. Cytoplasm.
靶标信息
Inducible co-stimulator ligand (ICOSL) is a specific ligand on antigen-presenting cells and cells of the peripheral tissue that binds to the inducible co-stimulator receptor (ICOS). ICOS belongs to the CD28/CD152 receptor family that regulates T-cell activation and function. ICOSL is expressed on monocytes, dendritic cells and B cells and can be induced by inflammatory stimuli in peripheral tissue. Binding to ICOSL delivers a co-stimulatory signal for T cell proliferation and cytokine secretion.
仅用于科研。不用于诊断过程。未经明确授权不得转售。
篇参考文献 (0)
生物信息学
蛋白别名: B7 homolog 2; B7 homologue 2; B7-H2; B7-like protein Gl50; B7-related protein 1; B7RP-1; CD275; ICOS ligand; ICOS-ligand; transmembrane protein B7-H2 ICOS ligand; unnamed protein product
基因别名: B7-H2; B7h; B7H2; B7RP-1; B7RP1; CD275; GL50; ICOS-L; ICOSL; ICOSLG; IMD119; KIAA0653; LICOS
UniProt ID: (Human) O75144
Entrez Gene ID: (Human) 23308